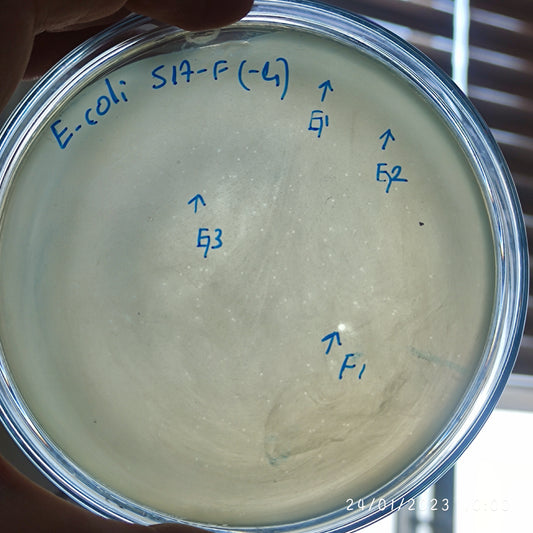
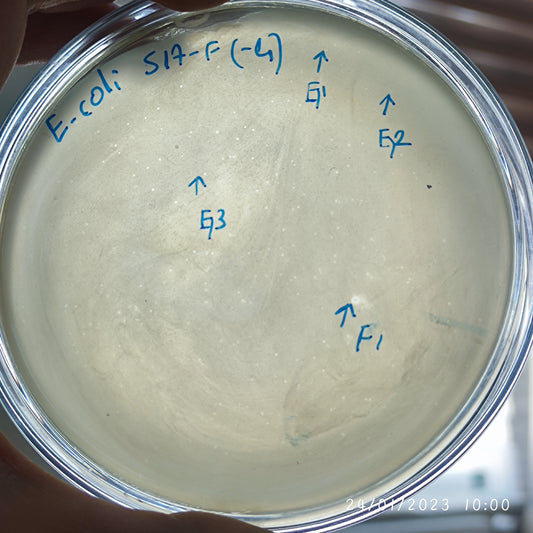
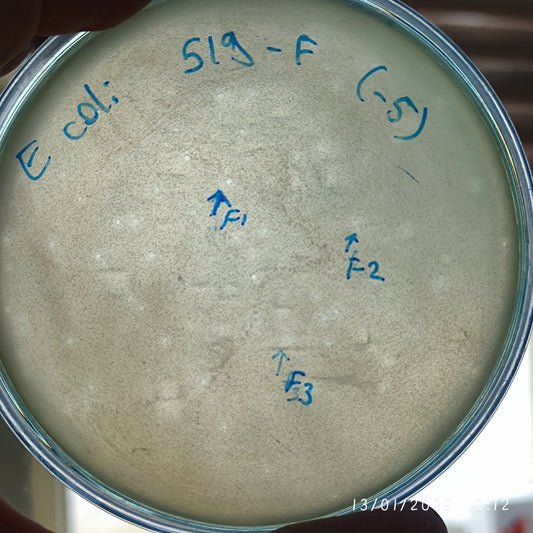
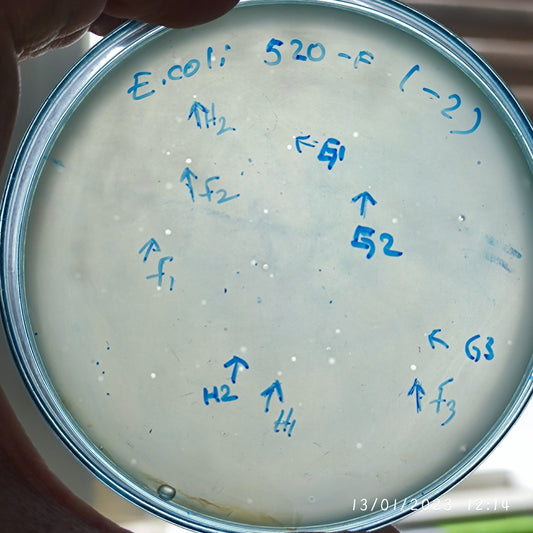
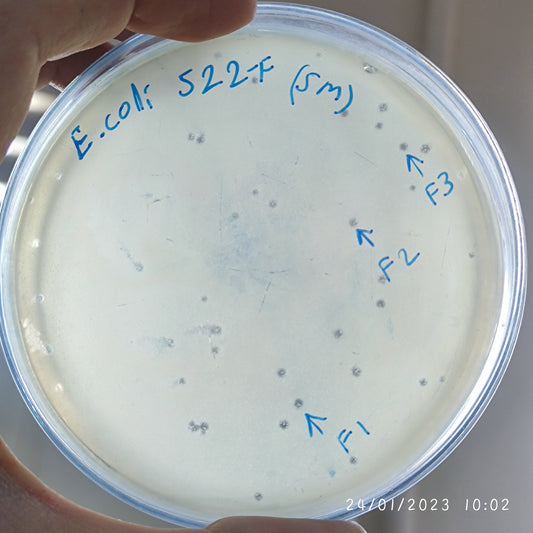
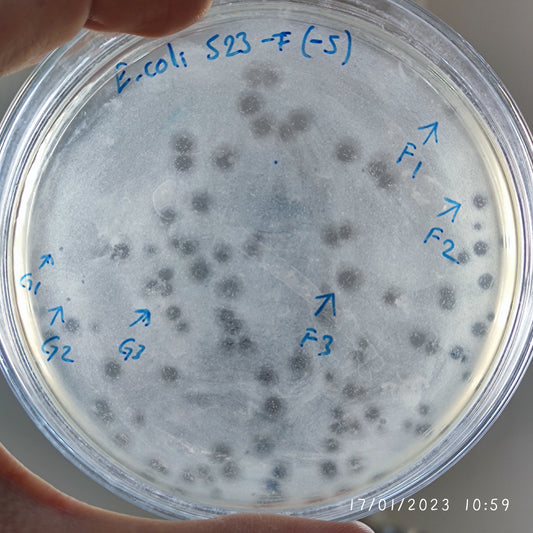
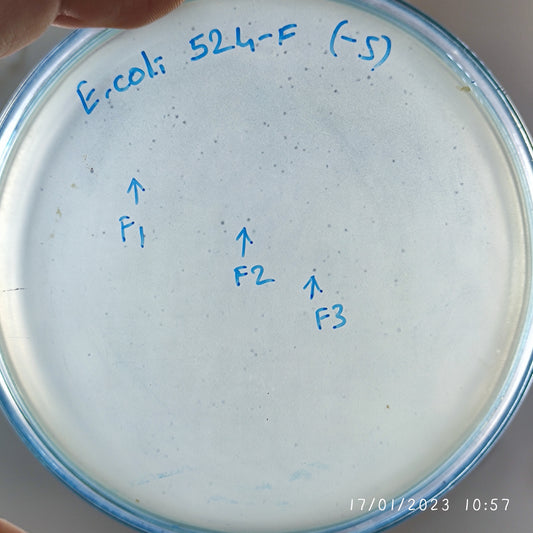
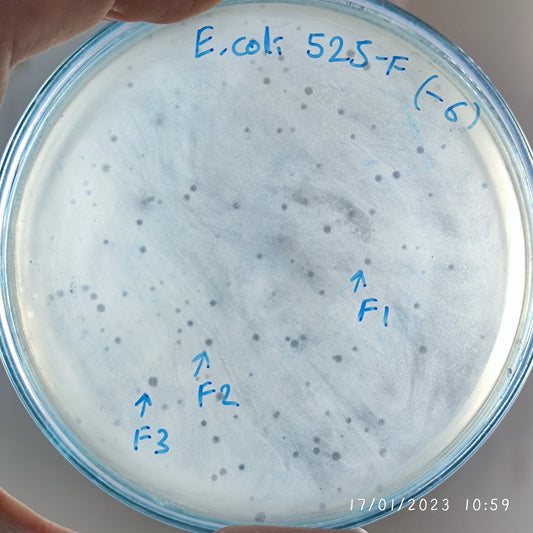
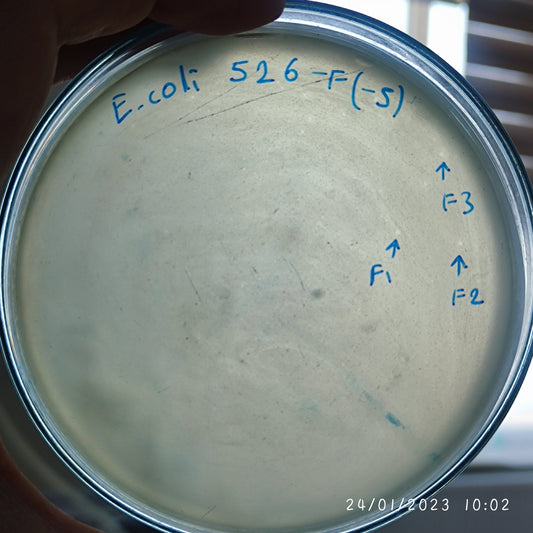
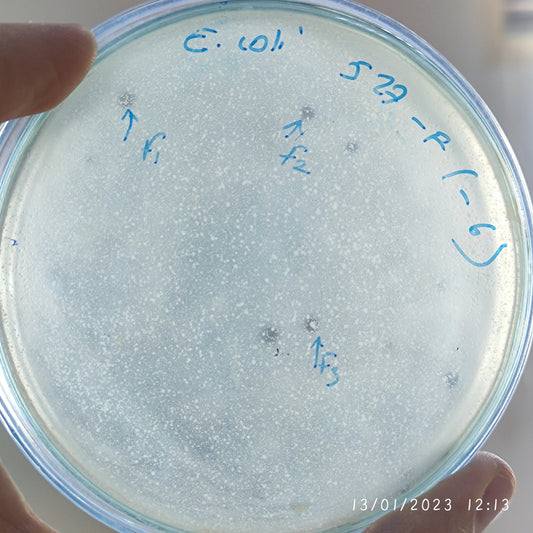
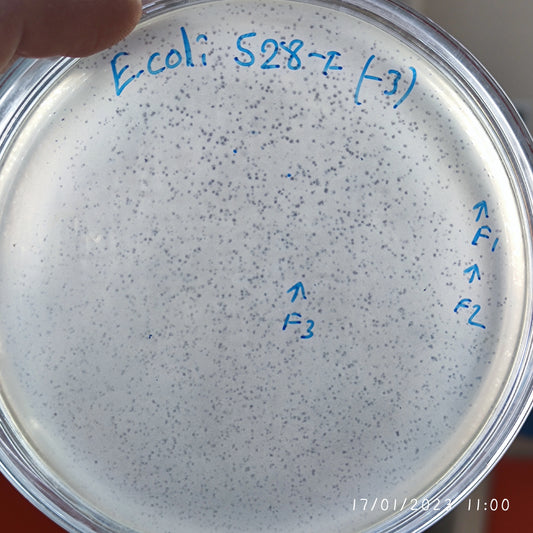

-
Escherichia coli bacteriophage 100517F
Regular price $750.00 USDRegular priceUnit price per -
Escherichia coli bacteriophage 100517G
Regular price $750.00 USDRegular priceUnit price per -
Escherichia coli bacteriophage 100518F
Regular price $750.00 USDRegular priceUnit price per -
Escherichia coli bacteriophage 100519F
Regular price $500.00 USDRegular priceUnit price per -
Escherichia coli bacteriophage 100520F
Regular price $500.00 USDRegular priceUnit price per -
Escherichia coli bacteriophage 100520G
Regular price $500.00 USDRegular priceUnit price per -
Escherichia coli bacteriophage 100520H
Regular price $500.00 USDRegular priceUnit price per -
Escherichia coli bacteriophage 100521F
Regular price $500.00 USDRegular priceUnit price per -
Escherichia coli bacteriophage 100522F
Regular price $750.00 USDRegular priceUnit price per -
Escherichia coli bacteriophage 100523F
Regular price $600.00 USDRegular priceUnit price per -
Escherichia coli bacteriophage 100523G
Regular price $500.00 USDRegular priceUnit price per -
Escherichia coli bacteriophage 100524F
Regular price $500.00 USDRegular priceUnit price per -
Escherichia coli bacteriophage 100525F
Regular price $500.00 USDRegular priceUnit price per -
Escherichia coli bacteriophage 100526F
Regular price $750.00 USDRegular priceUnit price per -
Escherichia coli bacteriophage 100527F
Regular price $500.00 USDRegular priceUnit price per -
Escherichia coli bacteriophage 100528F
Regular price $500.00 USDRegular priceUnit price per